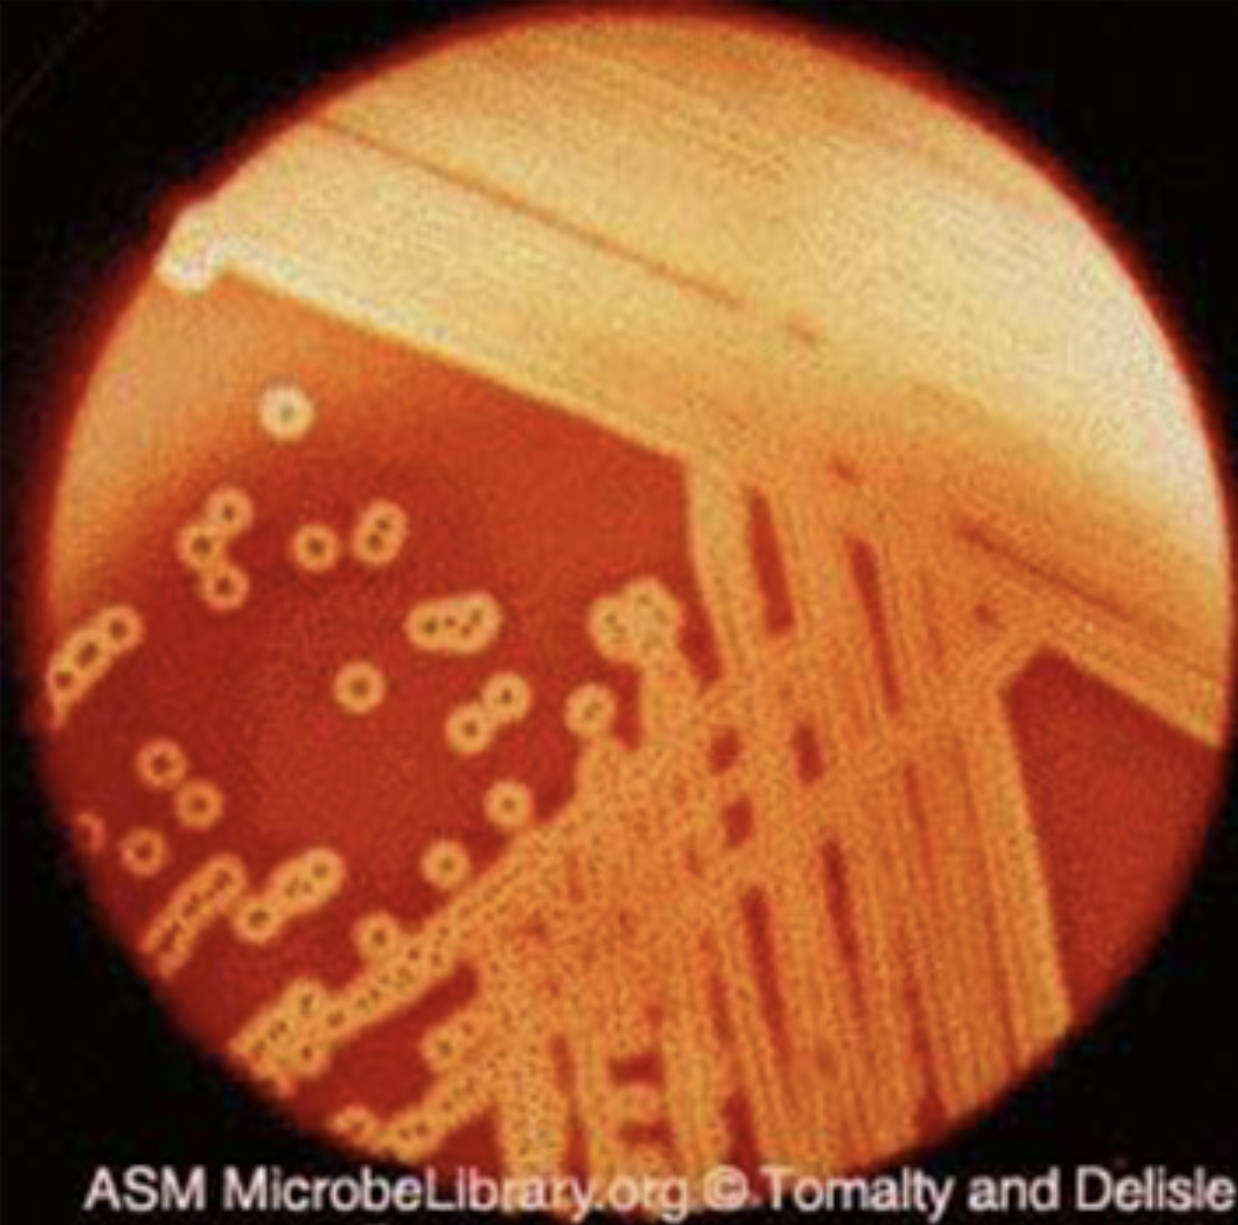

Streptococcus pyogenes, also known as Group A Streptococcus, ranks among the most important bacterial pathogens affecting humans worldwide. This Gram-positive coccus is renowned in clinical microbiology for its striking appearance on blood agar plates, where it produces distinctive zones of complete red blood cell destruction. The accompanying image provides a classic microscopic view of this phenomenon, captured through the lens of a culture plate and highlighting the organism’s hemolytic prowess under standard laboratory conditions.
Beta hemolysis refers to the complete lysis of erythrocytes surrounding bacterial colonies on blood agar, resulting in clear, transparent halos. This effect stems from the secretion of streptolysins that puncture red blood cell membranes, releasing hemoglobin and creating zones often two to four times larger than the colony itself. In the image, these prominent clearing areas against the red background confirm the beta-hemolytic property that aids rapid presumptive identification of S. pyogenes.
Colonies of S. pyogenes on blood agar are typically small, measuring 0.5 to 2 mm in diameter after 24 hours of incubation. They appear white to grayish, dome-shaped with smooth or moist surfaces and well-defined edges. The image reveals numerous such colonies, some isolated and others in proximity, each encircled by extensive hemolytic zones that stand out vividly on the enriched medium.
Red blood cells incorporated into the blood agar serve as an indicator substrate for detecting hemolytic activity. When exposed to S. pyogenes toxins, these cells undergo total disruption in the vicinity of growing colonies, producing the transparent effect visible throughout the plate. This complete clearing distinguishes beta hemolysis from partial or absent patterns seen in other streptococcal species.
The Role of S. pyogenes in Human Health
Group A Streptococcus colonizes the throat and skin of healthy individuals but can trigger a spectrum of diseases when host defenses are compromised. Common manifestations include pharyngitis and impetigo, while invasive forms encompass cellulitis, necrotizing fasciitis, and bacteremia. The bacterium’s virulence arsenal enables immune evasion and tissue invasion, making prompt laboratory identification essential for effective patient management.
In diagnostic workflows, blood agar culture remains a cornerstone technique. Plates are inoculated with clinical specimens such as throat swabs or wound samples and incubated aerobically at 35-37°C. After 24 hours, technologists scan for beta-hemolytic colonies exhibiting the morphology shown in the image. This visual cue triggers confirmatory tests, including bacitracin disk susceptibility, where S. pyogenes typically shows inhibition.
- Colonies often develop more pronounced hemolysis when plates are stabbed into the agar to create anaerobic microenvironments.
- Incubation in 5% CO2 can enhance growth and hemolytic expression for optimal visualization.
- The organism is catalase negative, further differentiating it from staphylococcal species that may appear similar on primary plates.
Microbiological Identification of Beta-Hemolytic Streptococcus
The image illustrates the hallmark laboratory presentation of S. pyogenes: pinpoint to small colonies surrounded by large zones of beta hemolysis. This pattern arises from the combined action of oxygen-stable streptolysin S and oxygen-labile streptolysin O, which together ensure thorough erythrocyte destruction. Observers note that light can often pass through the cleared zones, underscoring the completeness of the lysis process.
Colony size and shape provide additional clues. The smooth, glistening colonies visible in the micrograph contrast with the rougher or larger colonies of other beta-hemolytic organisms. Experienced microbiologists recognize that the hemolytic zone size relative to colony diameter is particularly exaggerated in S. pyogenes compared to many Group B or Group C streptococci.
Further identification may involve PYR testing, which yields a positive result for S. pyogenes, or Lancefield grouping via latex agglutination to confirm the Group A carbohydrate antigen. Molecular methods, including PCR targeting the speB or emm genes, offer rapid and specific confirmation in modern laboratories, especially for outbreak investigations or severe cases.
- Subsurface growth often reveals enhanced hemolysis due to reduced oxygen tension affecting streptolysin O activity.
- Colonies remain non-pigmented and lack the mucoid appearance sometimes seen in encapsulated strains.
- Proper lighting and plate tilting help appreciate the full extent of the clear hemolytic halos in the image.
Clinical Spectrum and Management of Infections
S. pyogenes infections demand swift attention because of their potential for rapid progression and post-infectious sequelae. Strep throat, while often self-limiting, can lead to rheumatic fever if untreated, damaging heart valves. Skin and soft tissue infections may escalate to toxic shock syndrome or necrotizing processes requiring aggressive surgical debridement alongside antibiotics.
Penicillin remains the drug of choice due to universal susceptibility, with treatment courses tailored to infection severity. For penicillin-allergic patients, alternatives include cephalosporins or clindamycin, the latter also inhibiting toxin production in severe cases. Supportive care addresses complications such as hypotension or organ failure in streptococcal toxic shock syndrome.
Public health measures focus on hygiene education, prompt treatment of index cases, and prophylaxis in high-risk settings like schools or households with rheumatic fever history. Surveillance tracks emm types to monitor strain virulence and antibiotic resistance trends, although beta-lactam resistance has not emerged significantly in this species.
The image serves as an educational anchor, reminding practitioners of the foundational culture characteristics that initiate the diagnostic cascade. Mastery of these visual features accelerates accurate identification, enabling timely intervention and reducing the burden of suppurative and nonsuppurative complications associated with this versatile pathogen.
Virulence Mechanisms Supporting Pathogenicity
Beyond hemolysins, S. pyogenes deploys M proteins that inhibit phagocytosis and promote adherence to host cells. The hyaluronic acid capsule camouflages the bacterium from immune detection, while exotoxins function as superantigens, driving cytokine storms responsible for rash and shock in scarlet fever or toxic shock. Enzymes such as streptokinase and DNase facilitate spread through tissues and evasion of neutrophil traps.
These factors explain the organism’s ability to cause both localized and systemic disease. The beta-hemolytic activity observed in the image not only aids laboratory detection but also contributes to tissue damage by lysing host cells and releasing nutrients for bacterial proliferation.
Ongoing research explores vaccine candidates targeting conserved regions of M protein or other surface antigens. Until effective immunization becomes available, reliance on classical microbiological techniques, exemplified by the clear beta-hemolytic zones in the provided image, continues to underpin clinical decision-making in infectious disease management.
By integrating visual recognition of colony features with clinical correlation, healthcare teams can optimize outcomes for patients affected by this significant bacterial pathogen. The educational value of such images lies in bridging laboratory observation with real-world medical application, fostering deeper understanding of microbial behavior and host-pathogen dynamics.

